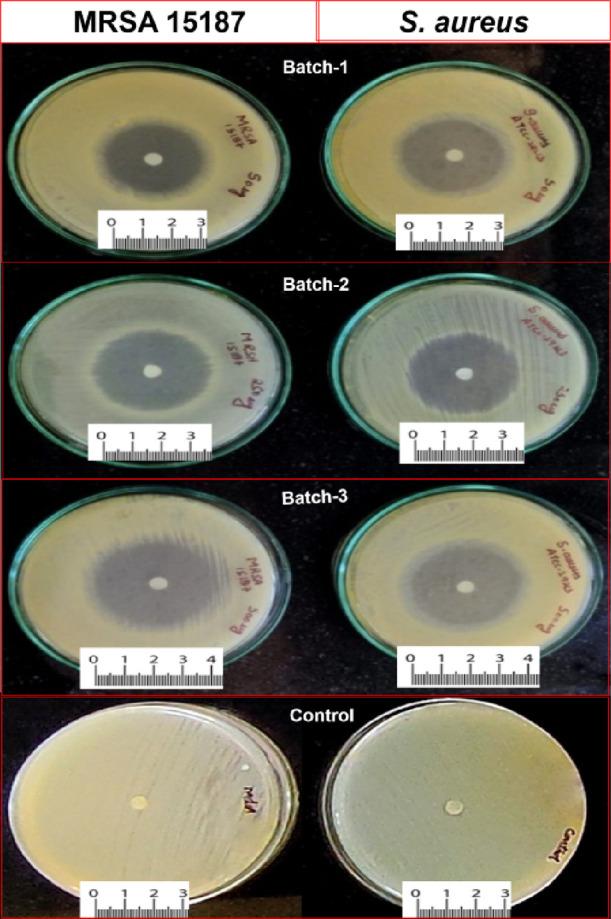
https://cdn.ncbi.nlm.nih.gov/pmc/blobs/d583/10851356/8fcb9c4a616a/ao3c07174_0003.jpg
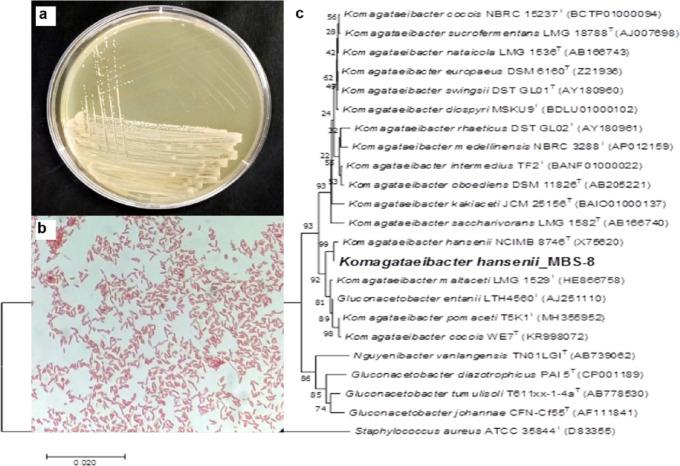
https://cdn.ncbi.nlm.nih.gov/pmc/blobs/d583/10851356/2f66ee682a6c/ao3c07174_0001.jpg

用于治疗皮肤感染的莫匹罗星浸渍细菌纤维素透皮贴剂的研发。
Development of Mupirocin-Impregnated Bacterial Cellulosic Transdermal Patches for the Management of Skin Infection.
作者信息
Bhat Rahul, Dogra Ashish, Chib Shifali, Kumar Manoj, Khan Inshad Ali, Nandi Utpal, Saran Saurabh
机构信息
Fermentation & Microbial Biotechnology Division, CSIR-Indian Institute of Integrative Medicine, Canal Road, Jammu, Jammu and Kashmir180001, India.
Clinical Microbiology Division, CSIR-Indian Institute of Integrative Medicine, Canal Road, Jammu, Jammu and Kashmir180001, India.
出版信息
ACS Omega. 2024 Jan 24;9(5):5496-5508. doi: 10.1021/acsomega.3c07174. eCollection 2024 Feb 6.
The present study reports the production of bacterial cellulose (BC) membranes using for the development of transdermal wound healing patches. BC-based transdermal patches were developed by impregnating varied concentrations of antibiotic mupirocin and characterized by SEM, FTIR, TGA, and DSC to study the interaction of BC with antibiotic. Developed patches were evaluated for antimicrobial activity, drug release study, efficacy, and acute dermal toxicity studies. The antibacterial activity of mupirocin-impregnated patches (mup-BC) showed an inhibition zone from 26.16 ± 0.76 to 35.86 ± 0.61 mm. The efficacy of mup-BC patches on the superficial abrasion mouse model infected with MRSA 15187 was determined. A single application of the mup-BC (Batch-3) showed a significant decrease up to 2.5 log colony-forming units (CFUs) in the infected skin. Acute dermal toxicity study showed no notable sign of toxicity. Pharmacokinetic study indicated that an application of mup-BC (Batch-3) showed a peak plasma concentration of around 1.5 μg/mL mupirocin. The overall preparation, ease of application, and efficacy results clearly indicate that the patches developed in the present study find immense application in the healthcare sector, especially for the treatment of burn or dermal wound infections.
本研究报道了利用细菌纤维素(BC)膜来开发用于透皮伤口愈合贴片的情况。通过浸渍不同浓度的抗生素莫匹罗星来制备基于BC的透皮贴片,并通过扫描电子显微镜(SEM)、傅里叶变换红外光谱(FTIR)、热重分析(TGA)和差示扫描量热法(DSC)对其进行表征,以研究BC与抗生素之间的相互作用。对所制备的贴片进行了抗菌活性、药物释放研究、疗效以及急性皮肤毒性研究。浸渍莫匹罗星的贴片(mup-BC)的抗菌活性显示抑菌圈为26.16±0.76至35.86±0.61毫米。测定了mup-BC贴片对感染耐甲氧西林金黄色葡萄球菌15187的浅表擦伤小鼠模型的疗效。单次应用mup-BC(批次3)显示感染皮肤中的菌落形成单位(CFU)显著减少高达2.5个对数。急性皮肤毒性研究未显示明显的毒性迹象。药代动力学研究表明,应用mup-BC(批次3)显示莫匹罗星的血浆峰值浓度约为1.5μg/mL。总体的制备、易于应用以及疗效结果清楚地表明,本研究中开发的贴片在医疗保健领域有广泛应用,特别是用于治疗烧伤或皮肤伤口感染。